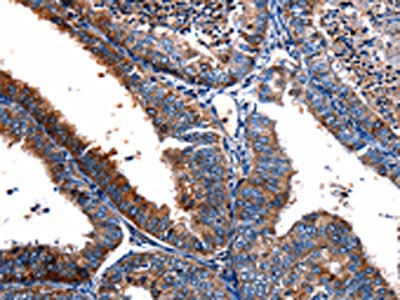

FPR2 Antibody
-
中文名稱:FPR2兔多克隆抗體
-
貨號:CSB-PA594474
-
規格:¥1100
-
圖片:
-
其他:
產品詳情
-
Uniprot No.:
-
基因名:
-
別名:FPR2; FPRH1; FPRL1; LXA4R; N-formyl peptide receptor 2; FMLP-related receptor I; FMLP-R-I; Formyl peptide receptor-like 1; HM63; Lipoxin A4 receptor; LXA4 receptor; RFP
-
宿主:Rabbit
-
反應種屬:Human
-
免疫原:Synthetic peptide of Human FPR2
-
免疫原種屬:Homo sapiens (Human)
-
標記方式:Non-conjugated
-
抗體亞型:IgG
-
純化方式:Antigen affinity purification
-
濃度:It differs from different batches. Please contact us to confirm it.
-
保存緩沖液:-20°C, pH7.4 PBS, 0.05% NaN3, 40% Glycerol
-
產品提供形式:Liquid
-
應用范圍:ELISA,IHC
-
推薦稀釋比:
Application Recommended Dilution ELISA 1:1000-1:10000 IHC 1:20-1:100 -
Protocols:
-
儲存條件:Upon receipt, store at -20°C or -80°C. Avoid repeated freeze.
-
貨期:Basically, we can dispatch the products out in 1-3 working days after receiving your orders. Delivery time maybe differs from different purchasing way or location, please kindly consult your local distributors for specific delivery time.
-
用途:For Research Use Only. Not for use in diagnostic or therapeutic procedures.
相關產品
靶點詳情
-
功能:Low affinity receptor for N-formyl-methionyl peptides, which are powerful neutrophil chemotactic factors. Binding of FMLP to the receptor causes activation of neutrophils. This response is mediated via a G-protein that activates a phosphatidylinositol-calcium second messenger system. The activation of LXA4R could result in an anti-inflammatory outcome counteracting the actions of proinflammatory signals such as LTB4 (leukotriene B4). Receptor for the chemokine-like protein FAM19A5, mediating FAM19A5-stimulated macrophage chemotaxis and the inhibitory effect on TNFSF11/RANKL-induced osteoclast differentiation. Acts as a receptor for humanin.
-
基因功能參考文獻:
- FPR2 promotes invasion and metastasis of gastric cancer cells and predicts the prognosis of patients. PMID: 28600569
- Phenol-soluble modulin (PSM) peptides from highly pathogenic Staphylococcus aureus are efficient ligands for FPR2. PMID: 28855276
- these results show that FPR2signaling interferes with the endosomal trafficking of influenza viruses and provides, for the first time, the proof of concept that monoclonal antibodies directed against FPR2 inhibit virus replication PMID: 29738458
- serum amyloid A (SAA) may stimulate the migration of SKOV3 cells through FPR2. The present study suggested that FPR2 promoted the invasion and metastasis of Epithelial ovarian cancer (EOC) and it could be a prognostic marker for EOC. PMID: 29039544
- plasma levels higher in preeclamptic women than in nonpregnant and normotensive pregnant women, and similar between nonpregnant and normotensive pregnant women PMID: 27179254
- Our findings provide evidence for defective LXA4 generation and FPR2/ALXR expression that, associated with increased LTB4, might be involved in a reduction in the ability of inhaled corticosteroids to impair control of airway inflammation in children with SA. PMID: 26971688
- These data show that viral replication and IAV pathogenesis depend on FPR2 signaling and suggest that FPR2 may be a promising novel strategy to treat influenza. PMID: 27034344
- Changes in the histone acetylation/methylation status enhanced FPR2 signaling in response to LXA4 during inflammation process. PMID: 27424221
- a novel FPR2 agonist, the proteolytically stable alpha-peptide/beta-peptoid hybrid Lau-((S)-Aoc)-(Lys-betaNphe)6-NH2 (F2M2), showing comparable potency in activating human and mouse neutrophils by inducing a rise in intracellular Ca(2+) concentration and assembly of the superoxide-generating NADPH oxidase. PMID: 27422818
- We conclude that ANX-A1 is an important regulator of mast cell reactivity to compound 48/80 exerting a negative feedback effect through a mechanism that depends at least partly on the FPR receptor PMID: 26803520
- pro-inflammatory stimuli lead to FPR2/ALX expression while LXA4 induces an anti-inflammatory response PMID: 26248046
- Data show that the purinergic receptor P2Y2 (P2Y2R) pepducin activates neutrophils through formyl peptide receptor 2 (FPR2), and ATP is turned into an activating agonist through a receptor cross-talk mechanism that involves both FPR2 and P2Y2R. PMID: 26996596
- Lipoxin A4 may have a role in preventing metabolic syndrome in a middle-aged Chinese population PMID: 26565966
- Serum amyloid A1alpha induces paracrine IL-8/CXCL8 via TLR2 and directly synergizes with this chemokine via CXCR2 and formyl peptide receptor 2 to recruit neutrophils. PMID: 26297794
- significant increase in expression of mRNA in placenta from women with pre-eclampsia PMID: 24960456
- ANXA1 may contribute to the regulation of tumor growth and metastasis through paracrine mechanisms that are mediated by FPR2/ALX PMID: 25490767
- Role of formyl peptide receptor 2 in homing of endothelial progenitor cells and therapeutic angiogenesis PMID: 25304660
- Expression of FPR2/ALX was analysed in 127 carotid atherosclerotic lesions and revealed that this receptor was expressed on macrophages, smooth muscle cells, and endothelial cells. PMID: 25341894
- There was an excessive maternal inflammatory response in preeclampsia. LXA4, ALX-R, and NF-kappaB p65 may be involved in the disease process ofpreeclampsia. PMID: 25864260
- Molecular determinants required for modulation of endocytic recycling in the anti-apoptotic function of FPR2/ALX. PMID: 25326384
- A stable peptidomimetic inhibited the activation of human neutrophils via direct interaction with FPR2. PMID: 25462815
- The effects of diclofenac on the incidence of pancreatitis following endoscopic retrograde cholangiopancreatography via lipoxin A4 and resolvin D1 and E1 levels is reported. PMID: 25030943
- Uteroglobin is a possible ligand of the lipoxin receptor and it may have a role in inhibiting serum amyloid A-driven inflammation PMID: 24782597
- The MAT-1 can induce chemotaxis specifically using FPR2, a receptor found on the surface of monocytes, macrophages and neutrophils. PMID: 24617769
- We also found that human mast cells expressed the N-formyl-peptide receptor 1 (FPRL1) receptor and FPRL1-specific inhibitor affected pleurocidin-mediated activation of mast cell. PMID: 23839065
- LXA decreased IgM and IgG production on activated human B cells through ALX/FPR2-dependent signaling. PMID: 24166736
- Structural determinants for the interaction of formyl peptide receptor 2 with peptide ligands. PMID: 24285541
- The H. pylori-derived peptide Hp(2-20) stimulated eosinophil migration through the engagement of FPR2 and FPR3, and also induced production of VEGF-A and TGF-beta, two key mediators of tissue remodelling. PMID: 24067461
- FPR2 is expressed in minor salivary glands with and without Sjogren's syndrome. PMID: 24259417
- lipoxin A4 may play a role in the resolution of upper airway inflammation. A low concentration of lipoxin A4 may be involved in chronic inflammation of the upper airways. PMID: 24358628
- Ligand-specific conformational change of the G-protein-coupled receptor ALX/FPR2 determines proresolving functional responses. PMID: 24108355
- FPR2 is not activated by lipoxin (LX)A; the molecular mechanism by which LXA functions still needs to be identified. PMID: 23643932
- Cross-talk between FPR2 and HGF receptor in human prostate epithelial cells. PMID: 23583448
- FPR2 is upregulated in peripheral blood mononuclear cells from patients with atherosclerosis. PMID: 23500463
- FPRL1 is responsible for TLR3 signaling induced by LL-37-poly(I:C). PMID: 23386607
- It was concluded that the ability of FPR2 to discriminate between the enantiomers is the consequence of the arrangement of three asymmetric hydrophobic subpockets at the main orthosteric FPR2 binding site. PMID: 23219934
- Most of the analyzed Enterococcus faecium but only sporadic Enterococcus faecalis strains released FPR2/ALX-stimulating molecules leading to neutrophil calcium ion fluxes, chemotaxis, and complement receptor upregulation. PMID: 22768166
- No evidence for the involvement of the lipoxin A4 receptor (FPR2/ALX ) gene in the susceptibility to coronary artery disease PMID: 22734147
- N-terminal region was dispensable for AnxA1-induced FPR2/ALX down-regulation in both the homologous and heterologous desensitization modes. PMID: 22610094
- Neutrophil activity induced by a cell-permeable peptide derived from the third intracellular loop of FPR2 is dose-dependently inhibited by membrane-permeable peptide inhibitor PBP10. PMID: 22706076
- Single-nucleotide polymorphism located in the intron of FPR2 is related to aspirin hypersensitivity in asthmatics. PMID: 22377711
- Results provide information on FPR2/ALX transcriptional regulation and evidence of mutations that affect FPR2/ALX transcription. PMID: 22131270
- These data support a model in which FPR2/ALX plays a role in chemotaxis and activation of monocytes; however, they also suggest that its function in resident tissue macrophages is limited. PMID: 22246625
- FPR2 has an appreciable pleiotropic regulator role in tumor immunoediting PMID: 21499310
- SAA up-regulates PTX3 production via FPRL1 significantly, and thus, contributes to the inflammatory pathogenesis of atherosclerosis. PMID: 21465531
- N-formyl peptide receptor 3 (FPR3) departs from the homologous FPR2/ALX receptor with regard to the major processes governing chemoattractant receptor regulation, expression at the cell surface, and phosphorylation. PMID: 21543323
- Data sugget the existence of an endogenous network in anti-inflammation centered on PMN AnxA1 and activated by selective FPR2/ALX agonists. PMID: 21398608
- the innate immune system may be able to respond in different ways to pathogenic or innocuous staphylococci by monitoring the presence of phenol-soluble modulins via FPR2. PMID: 21183593
- Data suggest that bacteria induce glial cell activation and rCRAMP expression via FPRL1 and MARCO, and these receptors contribute to the host defence against infection. PMID: 21299846
- The results indicate that SAA stimulates FPR2-mediated activation of p38 MAPK and JNK, which are independent of a pertussis toxin-sensitive G-protein and are essential for SAA-induced CCL2 production. PMID: 20177146
顯示更多
收起更多
-
亞細胞定位:Cell membrane; Multi-pass membrane protein.
-
蛋白家族:G-protein coupled receptor 1 family
-
組織特異性:Detected in lung, bone marrow, neutrophils, spleen and testis.
-
數據庫鏈接:
Most popular with customers
-
-
YWHAB Recombinant Monoclonal Antibody
Applications: ELISA, WB, IHC, IF, FC
Species Reactivity: Human, Mouse, Rat
-
Phospho-YAP1 (S127) Recombinant Monoclonal Antibody
Applications: ELISA, WB, IHC
Species Reactivity: Human
-
-
-
-
-